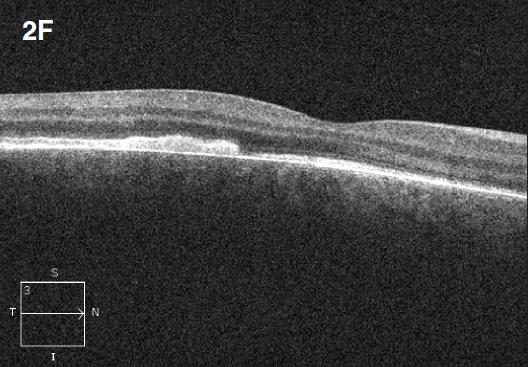

Considering the Treatment Options for Choroidal Hemangioma
The two types of this benign lesion dictate different treatment modalities.
Breno R. Lima, MD • Arun D. Singh, MD
Choroidal hemangioma is an uncommon vascular tumor of the choroid, which can be either circumscribed, generally presenting without systemic associations, or diffuse, often associated with Sturge-Weber syndrome (SWS). In some cases, localized prominence within a diffuse hemangioma may resemble a circumscribed hemangioma.1
Distinction between circumscribed and diffuse hemangioma is important, as there is a difference in the treatment approach between them. The aim of the treatment is to limit the visual compromise related to subretinal fluid and exudative retinal detachment or foveal distortion, due to the underlying tumor.
CIRCUMSCRIBED CHOROIDAL HEMANGIOMA
Choroidal hemangioma is most commonly diagnosed between the second and fourth decades of life, when the condition causes visual symptoms owing to the development of intraretinal edema and subretinal fluid. Clinically, it appears as an orange-red round or oval mass, often surrounded by a rim of slight pigmentation (Figure 1a). These hemangiomas are usually located in the posterior pole and are no thicker than 6 mm. Prominent intrinsic vessels are not seen, and retinal hard exudates are minimal or absent. Occasionally, choroidal hemangioma is misdiagnosed as choroidal metastasis, amelanotic cho roidal melanoma or choroidal granuloma.
Symptoms in choroidal hemangioma patients are highly variable, ranging from an asymptomatic lesion found incidentally to cases causing severe visual loss.
Imaging Studies
Ultrasonography and angiographic studies with fluorescein and indocyanine green (ICG) are helpful in establishing the diagnosis. The most common fluorescein angiography pattern is one of irregular linear hyperfluorescence of large choroidal vessels within the tumor during the prearterial and early arterial phases.2 There is progressive staining of the extravascular tissue of the tumor, with variable leakage in the late phase.
Indocyanine green demonstrates specific angiographic features, including early hyperfluorescence (Figure 1b), followed by late hypofluorescence (washout of dye) and a hyperfluorescent rim (Figure 1c).2
On B-scan ultrasonography, a circumscribed hemangioma appears as a dome-shaped choroidal mass with smooth contours (Figure 1d) and high internal reflectivity on Ascan (Figure 1e).
Treatment
Various modalities of treatment have been tried for the management of circumscribed choroidal hemangiomas, with varying degrees of success in stabilizing or improving visual acuity. Options include:
• cryotherapy3
• xenon arc and argon laser photocoagulation4
• transpupillary thermotherapy (TTT)5
• external beam radiotherapy6
• proton beam radiotherapy7
• plaque radiotherapy8
• photodynamic therapy9







Figure 1. Circumscribed choroidal hemangioma. A 45-year-old female presented with reduced vision in the right eye (20/40). A fundus exam revealed a dome-shaped choroidal mass (A). ICG demonstrated early hyperfluorescence (B, 1:15 minutes). Note hypofluorescence (washout of dye) with a hyperfluorescent rim in the late phase (C, 12:20 minutes). A dome-shaped choroidal mass with smooth contours was observed on B-scan ultrasonography (D) with high internal reflectivity on A-scan (E). One year after treatment with PDT, fundus evaluation showed a regressed hemangioma (F), which was confirmed on B-scan ultrasonography (G). Visual acuity improved to 20/20.

Figure 2. Diffuse choroidal hemangioma. The patient was a nine-year-old boy with history of Sturge-Weber syndrome, referred due to decreased vision (20/200) and subretinal fluid in the right eye. The fundus exam revealed retinal pigment epithelium mottling around the optic nerve with a surrounding cuff of subretinal fluid (A). B-scan ultrasonography demonstrated a solid, highly echogenic lesion, with diffuse choroidal thickening (B). OCT showed subretinal fluid with cystic spaces in the outer retinal layers (C). One year after treatment with external beam radiotherapy (20 Gy in 10 fractions, 2 Gy/fraction), the fundus exam revealed a regressed hemangioma (D). Tumor regression was confirmed by B-scan ultrasonography (E). Concomitant resolution of subretinal fluid was noted on OCT (F). Visual acuity improved to 20/60.
Treatment is indicated based upon the extent of symptoms, tumor location, presence of subretinal fluid and potential for visual recovery. Watchful waiting is a reasonable approach for asymptomatic extramacular lesions that do not have surrounding subretinal fluid. Given the limited potential for visual improvement, subfoveal hemangiomas with long-standing CME may also be observed.
Laser photocoagulation may induce resolution of subretinal fluid; however, it does not lead to significant tumor regression. Reduction in vision may occur, particularly when the tumor affects the foveal area.9
Transpupillary thermotherapy produces heat-induced sclerosis of the vascular channels in circumscribed choroidal hemangioma, resulting in tumor regression and resolution of the subretinal fluid. It may be used as a primary or secondary treatment. The endpoint of TTT is the complete improvement of the exudative detachment. Tumor regression may continue for several months after treatment. Among the reported complications are focal iris atrophy, CME and preretinal fibrosis. Therefore, TTT is not an ideal treatment for subfoveal hemangioma.5
Various radiotherapeutic methods, such as external beam radiotherapy,6 proton beam radiotherapy7 and plaque radiotherapy, have been reported to manage circumscribed choroidal hemangiomas successfully. In addition to tumor regression, absorption of subretinal fluid has been achieved in 67% to 100% of cases in patients treated with proton beam irradiation. Plaque radiotherapy (iodine 125,8 cobalt 60,10 and ruthenium 1068) has been shown to be successful in the resolution of subretinal fluid.
The complications of radiotherapy that must be considered are the development of cataracts, radiation maculopathy and radiation optic neuropathy, but the lower doses of radiation used appear to reduce the risk of complications without sacrificing treatment effects.9
In theory, PDT has ideal properties for the treatment of circumscribed choroidal hemangiomas, as it offers the capability for site-specific tumor destruction, allowing photochemical injury only to the vascular endothelial cells and sparing the overlying retina and retinal vasculature. It is the preferred treatment modality for juxtafoveal and subfoveal tumors, given the morbidity associated with other treatments for tumors at this location.11
Several clinical series have demonstrated favorable outcomes in patients treated with PDT. The choice of treatment parameters is a matter of debate, such as the technique of injection (bolus, injection over 10 minutes), radiant exposure (50-100 J/cm2), number of laser spots (single spot, multiple overlapping spots, or multiple nonoverlapping spots), number of treatment sessions (one to five, at intervals of 6-12 weeks), and duration of exposure (83-186 second).12 PDT not only eliminates the serous retinal detachments in almost all patients, but it also produces a marked reduction of the tumor height (Figures 1f and 1g).
In all studies, improvement or stabilization of visual acuity has been observed, suggesting PDT is an effective and safe method for the treatment of circumscribed choroidal hemangioma. Development of choroidal neovascularization has been documented in a single report.13 Retreatment should not be performed very early, as resolution of subretinal fluid may take several months. Delayed choroidal atrophy may occur with overtreatment. Optical coherence tomography may serve as a guide for follow-up of these tumors, allowing observation of subretinal fluid absorption or recurrence.14
DIFFUSE CHOROIDAL HEMANGIOMA
Diffuse choroidal hemangioma is a benign, vascular hamartoma that occurs in approximately 50% of patients with SWS. The syndrome is nonhereditary and is characterized by a nevus flammeus or “port wine stain” on the face and angioma of the meninges. These hemangiomas are usually unilateral and ipsilateral to the skin manifestations. SWS is also associated with various forms of glaucoma, due either to elevated episcleral venous pressure or angle maldevelopment, and retinal detachment.15
Clinically, diffuse choroidal hemangiomas present as generalized red-orange choroidal thickening, with or without an exudative retinal detachment (Figure 2a). These hemangiomas have been classically described as a “tomato catsup fundus.” There might be areas of excessive thickening, simulating circumscribed choroidal hemangiomas. In some cases, the lesions might be subtle, without welldefined borders, and may involve more than half of the fundus area.
Visual compromise is generally related to foveal distortion and exudative retinal detachment, which has a mean age of onset of eight years, as opposed to 39 years in circumscribed choroidal hemangiomas.16
Imaging Studies
B-scan ultrasonography demonstrates solid, highly echogenic lesions, with diffuse choroidal thickening (Figure 2b), and high internal reflectivity on A-scan. Early hyperfluorescence with persistence of hyperfluorescence through the late phases of the angiogram are seen with fluorescein angiography. Similar findings are observed on ICG, with a characteristic lacy intrinsic vascular pattern, with a diffuse distribution.16 OCT may be used to confirm the presence of subretinal fluid (Figure 2c).
Treatment
Observation may be considered for asymptomatic cases without subretinal fluid. The decision to treat should be based on the extent of subretinal detachment and potential for visual recovery.
External beam radiotherapy (Figures 2d-f), plaque radiotherapy, proton beam radiotherapy and PDT are among the modalities that have been used for the management of these lesions.17-19 Resolution of subretinal fluid and tumor regression have been documented with use of lowdose radiotherapy or proton beam irradiation.20 Schilling et al. reported the results of 15 patients treated with lesionsparing radiation (20 Gy, 2 Gy/fraction) with a mean follow-up of 5.3 years. Complete resolution of exudative detachment was achieved in all cases. Visual acuity was improved in seven patients.18
Potential complications of the use of radiation include the development of cataracts, radiation retinopathy, and optic neuropathy. Moreover, the lifetime risk of developing malignancies in association with radiation exposure in childhood should not be overlooked.17
There are six published cases of the use of PDT for the treatment for diffuse choroidal hemangioma.21 All the patients had improvement in visual acuity, with complete resolution of exudative retinal detachment. Treatment parameters have varied slightly, with the number of spots ranging from one to seven, the duration ranging from 60-83 seconds, the spot size ranging from 2,500 to 7,700 µm, with the same dose of verteporfin (6 mg/m2). In some cases, the fovea was treated.
However, some authors feel that treatment of the fovea should be avoided in order to reduce scarring and changes to the retinal pigment epithelium. In addition, there is concern for exudative response following PDT, which may cause transient loss of vision.21 While PDT has the advantage of avoiding radiation exposure, larger studies with longer-term follow-up are needed to determine treatment success better.15
CONCLUSION
Choroidal hemangiomas are uncommon, benign vascular tumors of the choroid. The treatment approach should be guided based on symptoms, location, presence of subretinal fluid, potential for visual improvement and the type of hemangioma. RP
REFERENCES
1. Singh AD, Kaiser PK. Uveal vascular tumors. In: Singh AD, Damato BE, Pe'er J, Murphree AL, Perry JD, eds. Clinical Ophthalmic Oncology. Philadelphia, PA: Saunders-Elsevier; 2007.
2. Arevalo JF, Shields CL, Shields JA, Hykin PG, De Potter P. Circumscribed choroidal hemangioma: characteristic features with indocyanine green videoangiography. Ophthalmology. 2000;107:344-350.
3. Humphrey WT. Choroidal hemangioma: Response to cryotherapy. Ann Ophthalmol. 1979;11:100-104.
4. Sanborn GE, Augsburger JJ, Shields JA. Treatment of circumscribed choroidal hemangiomas. Ophthalmology. 1982;89:1374-1380.
5. Gunduz K. Transpupillary thermotherapy in the management of circumscribed choroidal hemangioma. Surv Ophthalmol. 2004;49:3163-3127.
6. Ritland JS, Eide N, Tausjo J. External beam irradiation therapy for choroidal haemangiomas. Visual and anatomical results after a dose of 20 to 25 Gy. Acta Ophthalmol Scand. 2001;79:184-186.
7. Hannouche D, Frau E, Desjardins L, Cassoux N, Habrand JL, Offret H. Efficacy of proton therapy in circumscribed choroidal hemangiomas associated with serious retinal detachment. Ophthalmology. 1997;104:1780-1784.
8. Shields CL, Honavar SG, Shields JA, Cater J, Demirci H. Circumscribed choroidal hemangioma: clinical manifestations and factors predictive of visual outcome in 200 consecutive cases. Ophthalmology. 2001;108:2237-2248.
9. Anand R, Augsburger JJ, Shields JA. Circumscribed choroidal hemangiomas. Arch Ophthalmol. 1989;107:1338-1342.
10. Zografos L, Bercher L, Chamot L, Gailloud C, Raimondi S, Egger E. Cobalt-60 treatment of choroidal hemangiomas. Am J Ophthalmol. 1996;121:190-199.
11. Singh AD, Kaiser PK, Sears JE, Gupta M, Rundle PA, Rennie IG. Photodynamic therapy of circumscribed choroidal haemangioma. Br J Ophthalmol. 2004;88:1414-1418.
12. Blasi MA, Tiberti AC, Scupola A, et al. Photodynamic therapy with verteporfin for symptomatic circumscribed choroidal hemangioma: five-year outcomes. Ophthalmology. 2010;117:1630-1637.
13. Leys AM, Silva R, Inhoffen W, Tatar O. Neovascular growth following photodynamic therapy for choroidal hemangioma and neovascular regression after intravitreous injection of triamcinolone. Retina. 2006;26:693-697.
14. Zhang Y, Liu W, Fang Y, et al. Photodynamic therapy for symptomatic circumscribed macular choroidal hemangioma in Chinese patients. Am J Ophthalmol. 2010;150:710-715 e1.
15. Tsipursky MS, Golchet PR, Jampol LM. Photodynamic therapy of choroidal hemangioma in sturge-weber syndrome, with a review of treatments for diffuse and circumscribed choroidal hemangiomas. Surv Ophthalmol. 2011;56:68-85.
16. Turell ME, Singh AD. Vascular tumors of the retina and choroid: diagnosis and treatment. Mid East Afr J Ophthalmol. 2010;17:191-200.
17. Grant LW, Anderson C, Macklis RM, Singh AD. Low dose irradiation for diffuse choroidal hemangioma. Ophthalmic Genet. 2008;29:186-188.
18. Schilling H, Sauerwein W, Lommatzsch A, et al. Long-term results after low dose ocular irradiation for choroidal haemangiomas. Br J Ophthalmol. 1997;81:267-273.
19. Murthy R, Hanovaz SG, Naik M, Gopi S, Reddy VA. Ruthenium-106 plaque brachytherapy for the treatment of diffuse choroidal haemangioma in Sturge-Weber syndrome. Ind J Ophthalmol. 2005;53:274-275.
20. Singh AD, Kaiser PK, Sears JE. Choroidal hemangioma. Ophthalmol Clin North Am. 2005;18:151-161.
21. Singh AD, Rundle PA, Vardy SJ, Rennie IG. Photodynamic therapy of choroidal haemangioma associated with Sturge-Weber syndrome. Eye (Lond). 2005;19:365-367.
| Breno R. Lima, MD, is a senior resident in ophthalmology at the Cole Eye Institute of the Cleveland Clinic. Arun D. Singh, MD, is director of the Department of Ophthalmic Oncology at Cole. Neither author reports any financial interest in any products mentioned in this article. Dr. Singh can be reached via e-mail at singha@ccf.org. |








